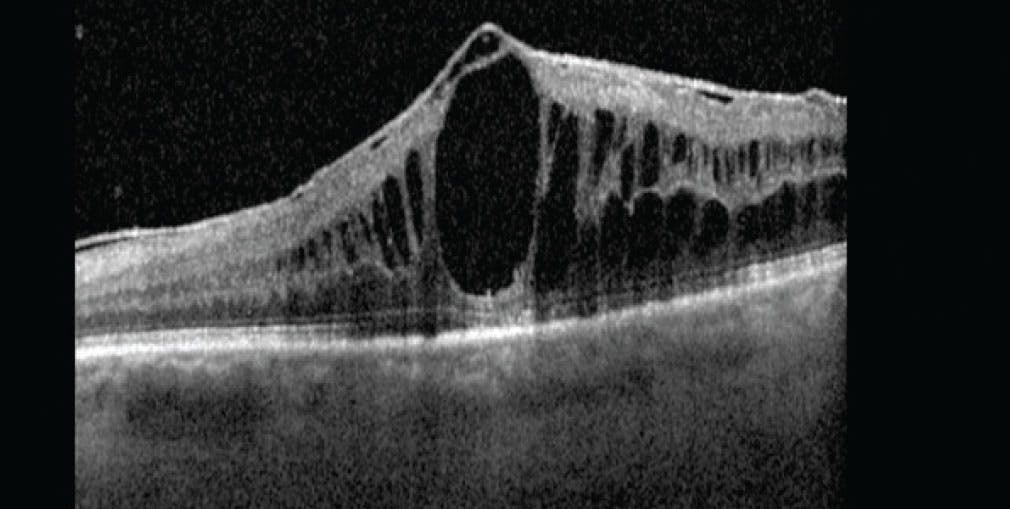

AT A GLANCE
- Local delivery mechanisms for steroids have been explored to mitigate the side effects of systemic steroids when treating uveitis.
- Biologics such as adalimumab are often used as additional agents following the failure of or incomplete response to conventional immunosuppressants in treating uveitis.
- Macular edema is a prevalent complication in uveitis, and several trials are exploring various treatment approaches.
Uveitis remains a significant cause of visual impairment, particularly in its severe forms.1 Here, we provide an update on completed and ongoing clinical trials in uveitis (Tables 1 and 2).
INITIAL TREATMENT CHOICES: NONINFECTIOUS UVEITIS
Traditional treatment for uveitis often involves immunosuppression with systemic corticosteroids, either alone or in conjunction with other antiinflammatory medications. This approach, however, is often fraught with severe side effects, including increased blood pressure, diabetes, and osteoporosis.2
To mitigate these side effects, local delivery mechanisms for steroids have been explored. In 2005, the FDA approved the intravitreal 0.59 mg fluocinolone acetonide intravitreal implant (Retisert, Bausch + Lomb). However, follow-up data up to 10 years from the MUST trial has since shown better visual acuity with systemic therapy over the implant and increased rates of visual impairment related to chorioretinal lesions, glaucoma, cataracts, and elevated IOP with the implant.3-6 Given these findings, it was concluded that systemic therapy is moderately superior to the fluocinolone implant for the treatment of noninfectious uveitis.
Newer-generation steroid implants, such as the 0.7 mg dexamethasone intravitreal implant (Ozurdex, Abbvie) and the 0.18 mg fluocinolone acetonide implant (Yutiq, Alimera Sciences), have introduced lower doses and are linked to fewer side effects, notably reduced rate of cataract progression and decreased need for glaucoma intervention.7 Current clinical trials are rigorously testing these implants in noninfectious intermediate and posterior uveitis, aiming to confirm their efficacy and safety profiles. These trials include monotherapy with the dexamethasone implant and one or two fluocinolone acetonide implants.8-10
EXPANDING OPTIONS WITH IMMUNOSUPPRESSANTS
The management of severe uveitis often includes an immunosuppressive agent.2 Antimetabolites are commonly used as first-line agents due to their affordability, favorable safety profile, and good patient tolerance. The FAST trial compared the efficacy and safety of two common immunosuppressants, methotrexate and mycophenolate mofetil, as first-line corticosteroid-sparing treatments. Results indicated similar efficacy in reducing treatment failure rate and time to steroid-sparing control of inflammation, as well as improving visual acuity and resolution of macular edema.11 Abnormalities in liver function tests were more common with methotrexate, and mycophenolate mofetil did not confer an additional risk of CD4 lymphopenia in patients with uveitis followed up to 12 months.11
A subanalysis of the FAST trial showed that patients with retinal vasculitis are more likely to experience treatment failure with both methotrexate and mycophenolate mofetil compared with patients without retinal vasculitis. Therefore, clinicians should consider other classes of corticosteroid-sparing medications, such as biologics, for these patients.11,12
THE GROWING ROLE OF BIOLOGICS
Biologics such as adalimumab are often used as additional agents following the failure of or incomplete response to conventional immunosuppressants in treating uveitis.
VISUAL I evaluated adalimumab as a glucocorticoid-sparing treatment for active noninfectious uveitis. Adalimumab extended the time to treatment failure (24 weeks vs 13 weeks for placebo), improved visual acuity, and reduced inflammation, although it led to more adverse events such as injection site and allergic reactions. Both groups experienced serious infections at similar rates.13
VISUAL II focused on preventing flare-ups in patients with inactive uveitis controlled by systemic corticosteroids. Adalimumab significantly reduced the risk of flare-ups and vision loss following corticosteroid withdrawal, showing a lower treatment failure rate (39% vs 55%) and a significantly longer time to treatment failure (> 18 months vs 8.3 months) compared with placebo.14
VISUAL III, an ongoing extension study, is evaluating the long-term safety and efficacy of adalimumab in patients from VISUAL I and II. Early results (78 weeks follow-up) are showing sustained quiescence and reduced corticosteroid use in most patients (60% to 90%).15
The SYCAMORE trial evaluated the efficacy of adalimumab in treating juvenile idiopathic arthritis (JIA)-associated uveitis in patients who were already receiving a stable dose of methotrexate (Figure 1). The trial found that adalimumab significantly lowered the rate of treatment failure compared with placebo (27% vs 60%), although it was associated with a higher incidence of adverse events.16

Figure 1. This 7-year-old patient presented with chronic anterior and intermediate uveitis with keratic precipitates, posterior synechiae, and early cataract in the right eye.
Additional ongoing trials are investigating anti-TNF agents as first-line treatments alone or in combination with other immunosuppressants for various forms of uveitis.17-24 Notable among these is the ADVISE trial comparing adalimumab with conventional immunosuppression as a first-line corticosteroid-sparing treatment in noninfectious, intermediate, posterior, and panuveitis and the ADJUST trial, which is assessing the feasibility of discontinuing adalimumab after stable disease control in JIA-associated uveitis.19,20
ADDRESSING A COMMON COMPLICATION
Macular edema is a prevalent complication in uveitis (Figure 2).1 The 7-year follow-up results of the MUST trial revealed that macular edema could be resolved in 94% of patients when treated, although approximately 50% experienced a relapse.25 Similarly, a 12-month follow-up subanalysis of the FAST trial indicated that 50% of patients in both groups showed some persistent macular edema at 12 months.26
The POINT trial compared three regional corticosteroid treatments: periocular triamcinolone acetonide, intravitreal triamcinolone acetonide, and the intravitreal dexamethasone implant. The results showed that intravitreal injections were more effective than periocular injections in reducing macular thickness and improving visual acuity, although they raised concerns due to potential side effects such as glaucoma and cataract formation.27
The MERIT trial compared the efficacy and safety of two alternative intravitreal treatments, methotrexate and ranibizumab (Lucentis, Regeneron), with the dexamethasone implant for managing persistent or recurrent uveitic macular edema in patients with minimally active or inactive noninfectious uveitis. At 12 weeks, dexamethasone proved superior in reducing macular thickness and improving vision, although it also posed a higher risk of increased IOP. The results also suggested its effect might diminish before 12 weeks, indicating a potential need for earlier retreatment. Results from the 24-week follow-up are pending.28
Given the ongoing concerns about the side effects associated with intraocular steroids, alternative approaches have been investigated. The PEACHTREE trial evaluated the efficacy and safety of suprachoroidal triamcinolone acetonide injectable suspension (Xipere, Bausch + Lomb and Clearside Biomedical) in improving vision in patients with noninfectious uveitis complicated by macular edema over 12 weeks, finding that it significantly improved vision with a lower rate of IOP elevation compared with dexamethasone implants in the MERIT trial.29 Additionally, the MAGNOLIA study, an observational extension of the PEACHTREE trial over 24 weeks, showed that the beneficial effects of suprachoroidal triamcinolone acetonide lasted up to 6 months, with glaucoma and cataract rates similar to those seen in sham treatments.30 A post-hoc analysis of the PEACHTREE trial further evaluated the safety and efficacy of suprachoroidal triamcinolone acetonide in treating uveitic macular edema, comparing patients with and without systemic corticosteroids or steroid-sparing therapies at baseline. This analysis revealed no significant safety issues between the groups and confirmed that suprachoroidal triamcinolone acetonide significantly enhanced both visual and anatomical outcomes, irrespective of patients’ baseline systemic therapy status.31
FUTURE DIRECTIONS AND ONGOING TRIALS
As uveitis treatment evolves, integrating new findings is crucial. Treatment choices—systemic, implant-based, or biologic—are tailored based on each patient’s specific needs. Ongoing research aims to refine and enhance these strategies for better outcomes.
1. Kempen JH, Van Natta ML, Altaweel MM, et al. Factors predicting visual acuity outcome in intermediate, posterior, and panuveitis: The Multicenter Uveitis Steroid Treatment (MUST) trial. Am J Ophthalmol. 2015;160:1133-1141.e9.
2. Jabs DA, Rosenbaum JT, Foster CS, et al. Guidelines for the use of immunosuppressive drugs in patients with ocular inflammatory disorders: recommendations of an expert panel. Am J Ophthalmol. 2000;130(4):492-513.
3. Kempen JH, Altaweel MM, Holbrook JT, et al. Randomized comparison of systemic anti-inflammatory therapy versus fluocinolone acetonide implant for intermediate, posterior and panuveitis: The Multicenter Uveitis Steroid Treatment trial. Ophthalmology. 2011;118(10):1916-1926.
4. Kempen JH, Altaweel MM, Holbrook JT, Sugar EA, Thorne JE, Jabs DA. Association between long-lasting intravitreous fluocinolone acetonide implant vs systemic anti-inflammatory therapy and visual acuity at 7 years among patients with intermediate, posterior, or panuveitis. JAMA. 2017;317(19):1993-2005.
5. Kempen JH, Van Natta ML, Friedman DS, et al. Incidence and outcome of uveitic glaucoma in eyes with intermediate, posterior, or panuveitis followed up to 10 years after randomization to fluocinolone acetonide implant or systemic therapy. Am J Ophthalmol. 2020;219:303-316.
6. Chattopadhyay A, Rathinam SR, Gonzales JA, et al. Association between quality of life and visual acuity in a randomized clinical trial of patients with uveitis taking antimetabolites. Ocul Immunol Inflamm. 2024;32(3):301-309.
7. Arcinue CA, Cerón OM, Foster CS. A comparison between the fluocinolone acetonide (Retisert) and dexamethasone (Ozurdex) intravitreal implants in uveitis. J Ocul Pharmacol Ther. 2013;29(5):501-507.
8. Ozurdex Monotherapy Trial. Accessed May 30, 2024. classic.clinicaltrials.gov/ct2/show/NCT05101928
9. The use of two YUTIQ versus sham for treatment of chronic non infectious intraocular inflammation affecting the posterior segment. Accessed May 30, 2024. clinicaltrials.gov/study/NCT05486468
10. Fluocinolone acetonide intravitreal implant 0.18 mg in the treatment of chronic non-infectious posterior segment uveitis. Accessed May 30, 2024. clinicaltrials.gov/study/NCT05322070
11. Rathinam SR, Gonzales JA, Thundikandy R, et al. Effect of corticosteroid-sparing treatment with mycophenolate mofetil vs methotrexate on inflammation in patients with uveitis: a randomized clinical trial. JAMA. 2019;322(10):936-945.
12. Reddy AK, Miller DC, Sura AA, et al. Risk of failing both methotrexate and mycophenolate mofetil from the First-line Antimetabolites as Steroid-sparing Treatment (FAST) uveitis trial. J Ophthalmic Inflamm Infect. 2023;13(1):29.
13. Jaffe GJ, Dick AD, Brézin AP, et al. Adalimumab in patients with active noninfectious uveitis. N Engl J Med. 2016;375(10):932-943.
14. Nguyen QD, Merrill PT, Jaffe GJ, et al. Adalimumab for prevention of uveitic flare in patients with inactive non-infectious uveitis controlled by corticosteroids (VISUAL II): a multicentre, double-masked, randomised, placebo-controlled phase 3 trial. Lancet. 2016;388(10050):1183-1192.
15. Suhler EB, Adán A, Brézin AP, et al. Safety and efficacy of adalimumab in patients with noninfectious uveitis in an ongoing open-label study: VISUAL III. Ophthalmology. 2018;125(7):1075-1087.
16. Ramanan AV, Dick AD, Jones AP, et al. Adalimumab plus methotrexate for uveitis in juvenile idiopathic arthritis. N Engl J Med. 2017;376(17):1637-1646.
17. Efficacy, safety and costs of methotrexate, adalimumab, or their combination in non-infectious non-anterior uveitis. Accessed May 30, 2024. clinicaltrials.gov/study/NCT04798755
18. Adalimumab vs. conventional immunosuppression for uveitis trial. Accessed May 30, 2024. clinicaltrials.gov/study/NCT03828019
19. Adalimumab in JIA-associated uveitis stopping trial. Accessed May 30, 2024. clinicaltrials.gov/study/NCT03816397
20. Acharya NR, Ebert CD, Kelly NK, et al. Discontinuing adalimumab in patients with controlled juvenile idiopathic arthritis-associated uveitis (ADJUST-Adalimumab in Juvenile Idiopathic Arthritis-associated Uveitis Stopping Trial): study protocol for a randomised controlled trial. Trials. 2020;21:887.
21. A study to assess change in disease activity and adverse events of adalimumab in Chinese participants requiring high dose corticosteroids for active non-infectious intermediate, posterior, or pan-uveitis. Accessed May 30, 2024. clinicaltrials.gov/study/NCT05414201
22. A clinical trial of infliximab for childhood uveitis. Accessed May 30, 2024. clinicaltrials.gov/study/NCT04150770
23. The efficacy and safety of adalimumab in non-infectious anterior pediatric uveitis with peripheral vascular leakage. Accessed May 30, 2024. clinicaltrials.gov/study/NCT05015335
24. Biologic therapy in pediatric JIA uveitis. Accessed May 30, 2024. clinicaltrials.gov/study/NCT05540743
25. Tomkins-Netzer O, Lightman SL, Burke AE, et al. Seven-year outcomes of uveitic macular edema: the Multicenter Uveitis Steroid Treatment (MUST) Trial and follow-up study results. Ophthalmology. 2021;128:719.
26. Tsui E, Rathinam SR, Gonzales JA, et al. Outcomes of uveitic macular edema in the first-line antimetabolites as steroid-sparing treatment uveitis trial. Ophthalmology. 2022;129(6):661-667.
27. Thorne JE, Sugar EA, Holbrook JT, et al. Periocular triamcinolone vs. intravitreal triamcinolone vs. intravitreal dexamethasone implant for the treatment of uveitic macular edema: the PeriOcular vs. INTravitreal corticosteroids for uveitic macular edema (POINT) trial. Ophthalmology. 2019;126(2):283-295.
28. Acharya NR, Vitale AT, Sugar EA, et al. Intravitreal therapy for uveitic macular edema—ranibizumab versus methotrexate versus the dexamethasone implant: the MERIT trial results. Ophthalmology. 2023;130(9):914-923.
29. Yeh S, Khurana RN, Shah M, et al. Efficacy and safety of suprachoroidal CLS-TA for macular edema secondary to noninfectious uveitis: phase 3 randomized trial. Ophthalmology. 2020;127(7):948-955.
30. Khurana RN, Merrill P, Yeh S, et al. Extension study of the safety and efficacy of CLS-TA for treatment of macular oedema associated with non-infectious uveitis (MAGNOLIA). Br J Ophthalmol. 2022;106(8):1139-1144.
31. Merrill PT, Henry CR, Nguyen QD, Reddy A, Kapik B, Ciulla TA. Suprachoroidal CLS-TA with and without systemic corticosteroid and/or steroid-sparing therapy: a post-hoc analysis of the phase 3 PEACHTREE clinical trial. Ocul Immunol Inflamm. 2023;31(8):1579-1586.
32. Lowder C, Belfort R, Lightman S, et al. Dexamethasone intravitreal implant for noninfectious intermediate or posterior uveitis. Arch Ophthalmol. 2011;129(5):545-553.
33. Merrill PT, Clark WL, Banker AS, et al. Efficacy and safety of intravitreal sirolimus for noninfectious uveitis of the posterior segment: results from the Sirolimus Study Assessing Double-Masked Uveitis Treatment (SAKURA) program. Ophthalmology. 2020;127(10):1405-1415.
34. Efficacy, safety and costs of methotrexate, adalimumab, or their combination in non-infectious non-anterior uveitis. Accessed May 30, 2024. clinicaltrials.gov/study/NCT04798755
35. A study of baricitinib (LY3009104) in participants from 2 years to less than 18 years old with active JIA-associated uveitis or chronic anterior antinuclear antibody-positive uveitis. Accessed May 30, 2024. clinicaltrials.gov/study/NCT04088409
36. A study of TRS01 in subjects with active non-infectious anterior uveitis including subjects with uveitic glaucoma. Accessed May 30, 2024. clinicaltrials.gov/study/NCT05042609
37. Systemic and topical antivirals for control of cytomegalovirus anterior uveitis: treatment outcomes. Accessed May 30, 2024. clinicaltrials.gov/study/NCT03586284
38. Preventing extension of oligoarticular juvenile idiopathic arthritis JIA (Limit-JIA). Accessed May 30, 2024. clinicaltrials.gov/study/NCT03841357
39. LUMINA phase III study assessing the efficacy and safety of intravitreal injections of 440 ug DE-109 sirolimus for the treatment of active, non-infectious uveitis of the posterior segment of the eye. Accessed May 30, 2024. clinicaltrials.gov/study/NCT03711929
40. The efficacy and safety of adalimumab in non-infectious anterior pediatric uveitis with peripheral vascular leakage. Accessed May 30, 2024. clinicaltrials.gov/study/NCT05015335
41. Topical 2% ganciclovir eye drop for CMV anterior uveitis / endotheliitis. Accessed May 30, 2024. clinicaltrials.gov/study/NCT02943057